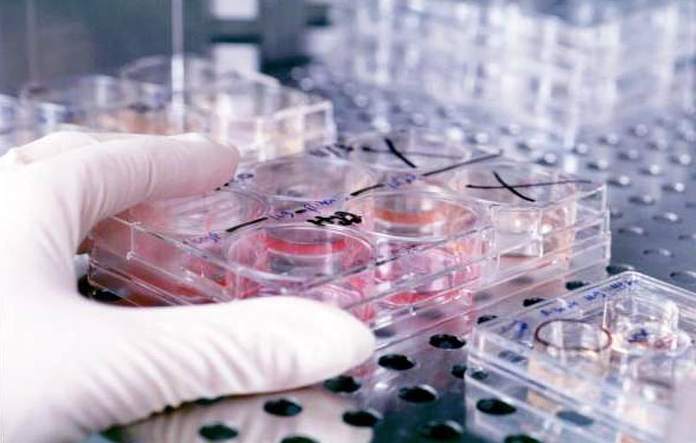

Las muertes por cáncer, enfermedad que ya es la segunda causa de decesos en Latinoamérica, aumentarán un 106 por ciento en 2030 si no hay cambios significativos en la política sanitaria de la región, según un informe elaborado por la unidad de inteligencia de The Economist.
"Estos resultados nos obligan a tener una visión común para enfrentar el desafío, ya que en la región hay muchas prioridades de salud y los recursos son limitados", explicó Irene Mia, autora del reporte y directora editorial global de liderazgo de reflexión del semanario británico The Economist.
El informe titulado ‘El Control del Cáncer, acceso y desigualdad en América Latina: una historia de luces y sombras’ fue presentado en el Roche Press Day, un foro sobre los últimos avances de la medicina en la región, que culmina hoy en Buenos Aires.
Para su elaboración se hizo una investigación de los datos disponibles en 12 países: México, Costa Rica, Panamá, Colombia, Ecuador, Brasil, Perú, Paraguay, Chile, Bolivia, Uruguay y Argentina. El informe indica que entre el 60% y el 70% de los pacientes de la región son diagnosticados en estados avanzados de la enfermedad.
También señala que cada año se suman a la lista un millón de nuevos casos de cáncer y casi el 70% de las muertes que se producen por la enfermedad ocurren en los estratos de ingreso mediano y bajo, lo que refleja las desigualdades en la región.
Los países en general tienen una baja disponibilidad a los medicamentos de última generación. De la zona, sólo Chile dispone de los fármacos más avanzados para tratar el cáncer de pulmón. Además, solo dos naciones, Chile y Uruguay, tienen suficientes equipos de radioterapia para tratar a todos sus pacientes.
El documento explica también que en la región existe más riesgo de que se desarrolle cáncer de mama y de próstata. También se ha registrado una disminución en la incidencia de cáncer de hígado y estómago.
Sólo Argentina, Costa Rica, Panamá y Uruguay tienen registros de base poblacional a nivel nacional, mientras que en México, Perú y Ecuador solo se cuenta con registros hospitalarios. Y únicamente Costa Rica y Brasil tienen una cobertura universal de salud, mientras que México, Argentina y Paraguay tienen centros de atención gratuita.
